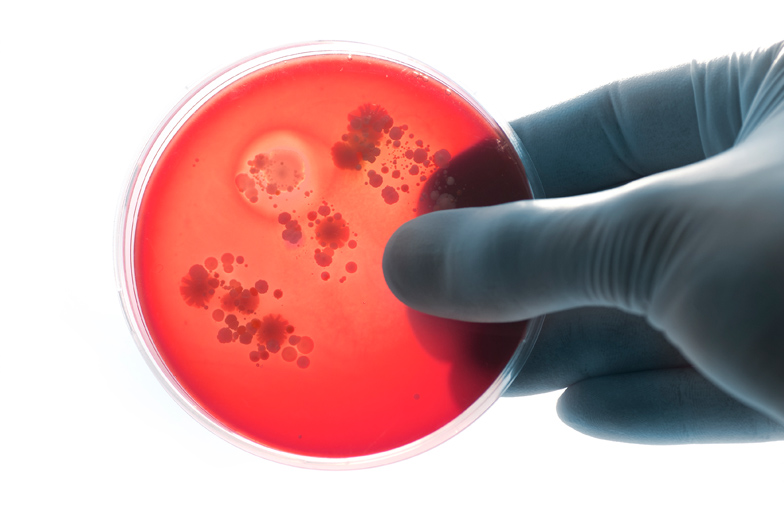
Petrischale mit Nährstoffträger für Analyse Schimmelpilzbefall

Meine Leistungen
Schimmelpilzbewertung
Nässeschäden-Begutachtung
und Sanierungskontrolle
Schimmelpilzbewertung
Schimmelpilze sind ein natürlicher Teil unserer belebten Umwelt und Ihre Sporen sind daher auch in allen Innenräumen vorhanden. Vermieden werden sollte eine erhöhte Konzentration von Schimmelpilzen durch Schimmelwachstum im Innenraum. Ursachen für eine erhöhte Konzentration von Schimmelpilzen in Innenräumen sind meistes auf Baumängel, Wärme-brücken, Wasserschäden oder fehlerhaftes Lüften zurückzuführen.
Zur Untersuchung, zum Nachweis und der Bewertung von Schimmelpilzen in Innenräumen hat der Sachverständige folgende Möglichkeiten:
- Bei sichtbaren Schimmelbefall kann vom Sachverständigen eine Materialprobe entnommen werden, um diese auf eine mögliche gesundheitsgefährdende Belastung durch ein Analyselabor prüfen zu lassen
- Bei Verdacht auf Schimmelbefall durch z.B. muffigen Geruch können durch Luftproben die Belastung der Raumluft analysiert werden.
- Messung von Bauteilfeuchte. Die meisten Arten von Schimmelpilzen, welche in Innenräumen auftreten benötigen zum Wachstum Feuchtigkeit. Zum Abschätzen des Ausmaßes kann durch moderne Messtechnik die Feuchtigkeit im Bauteil analysiert werden.
- Anhand der entnommenen Proben kann durch ein Analyselabor für Mikrobiologie eine ausführliche schriftliche Auswertung erstellt werden.
- Schadensaufnahme nach Vorgaben des Umweltbundes Amts mit entsprechenden Begehungsberichts
- Erstellen eines Gutachtens zur Bewertung des Schimmelpilzschadens
- Erstellung einer Ergebnisdarstellung mit entsprechenden Sanierungs-konzept in dem die Maßnahmen für eine fachgerechte Sanierung vorgeschlagen werden.

Sanierungskontrolle nach einer Schimmelpilzsanierung
Ziel einer Schimmelpilzsanierung sollte die Entfernung der mit Schimmelpilz bewachsenen Materialien sein und die durch das Wachstum möglicher-weise kontaminierten Oberflächen so weit zu reinigen, dass diese für den angedachten Gebrauch wieder verwendet werden dürfen.
Die Sanierungskontrolle besteht aus einer Objekt-Begehung und der visuellen Inspektion des Sanierungsbereichs. Nach der visuellen Kontrolle wird die Raumluft mobilisiert (d.h. die bearbeiteten Flächen werden zu ca. 50% mit einem Ventilator angeblasen, um eventuelle noch vorhanden Schwebstoffe aufzuwirbeln) die mobilisierte Raumluft wird anschließend angesaugt, die angesaugten Partikel werden auf einen Nährstoffträger gesammelt und zur Auswertung in ein Analyselabor gesendet.
Nässeschäden
Bei der Bewertung, Begutachtung und Begleitung bei der Beseitigung von Nässeschäden ist die Unterstützung durch einen Sachverständigen anzuraten. Das Wachstum von Schimmelpilzen in Innenräumen ist häufig auf feuchte und durchnässte Bauteile zurückzuführen. Ursachen für einen feuchten Baustoff können Bau-Mängel, Leckagen, Wärmebrücken und falsches Lüften sein.
Um einer umfangreichen Sanierung vorzubeugen, ist es wichtig die Ursachen der Feuchtigkeit zu beseitigen und rechtzeitig die richtigen Maßnahmen zur Trocknung der Oberflächen und den betroffenen Bauteilen einzuleiten.
Hierbei kann Sie der Sachverständige bei umgehender Einbeziehung unterstützen, die richtigen Maßnahmen zur Minimierung der Sanierungskosten einzuleiten und ggf. prüfen, ob eine eventuelle Regulierungspflicht seitens des Versicherers besteht.


Untersuchung der Raumluft auf Schimmelpilze
Bei Verdacht auf verdeckten Schimmelpilzbefall, bei bereits sichtbarem Schimmelpilzbefall zur Festlegung des Sanierungsumfangs, zur Kontrolle nach einer Schimmelpilzsanierung sowie bei hygienischen Untersuchungen von RLT-Anlagen und Lüftungssystemen nach VDI 6022 ist eine Untersuchung der Raumluft auf Schimmelpilzsporen wichtig.
Ob und in welchem Umfang Messungen sinnvoll sind, kann telefonisch oder bei einem Ortstermin geklärt werden.
Luftkeimsammlung
Die Luftkeimsammlung zur Schimmelpilzanalyse ist ein Verfahren zur Identifizierung und Quantifizierung von Schimmelpilzsporen in der Luft. Ziel ist die Beurteilung der Luftqualität in Innenräumen oder auch im Freien hinsichtlich der Belastung mit Schimmelpilzen.
Bei der Luftkeimsammlung wird ein definiertes Luftvolumen mit einem Luftkeimsammler durch eine oder mehrere Sammelvorrichtungen geleitet und auf eine Petrischale geschleudert.
Nach der Probenahme werden die Sammelmedien inkubiert, um das Wachstum von Schimmelpilzkolonien zu ermöglichen. Nach einer bestimmten Inkubationszeit können die Kolonien gezählt und identifiziert werden, um die Konzentration und Art der Schimmelpilze in der Luftprobe zu bestimmen.


Partikelsammlung
Die Luftpartikelsammlung zur Schimmelpilzanalyse ist ein Verfahren zur Erfassung von Schimmelpilzsporen. Ziel ist die Beurteilung der Luftqualität in Innenräumen oder auch im Freien hinsichtlich der Belastung mit Schimmelpilzen.
Dieses Verfahren ist von besonderer Bedeutung, da reizende, toxische und sensibilisierende Wirkungen von luftgetragenen Pilzsporen sowohl von kultivierbaren als auch von nicht kultivierbaren Sporen ausgehen können. Die Bestimmung der Gesamtzahl von Schimmelpilzsporen durch nicht kultivierte Verfahren ist daher in vielen Fällen sinnvoll.
Eine Schimmelpilzart wie Stachybotrys chartarum, die Mykotoxine bilden kann, kann oft nicht durch Kultivierung, sondern nur durch direkte Bestimmung der Gesamtsporenzahl nachgewiesen werden. Die Bestimmung der Gesamtsporenzahl erfolgt durch Schlitzdüsenimpfung auf beschichteten Objektträgern. Dabei werden luftgetragene Sporen auf einem beschichteten Objektträger fixiert und nach Anfärbung mikroskopisch ausgewertet. Ein großer Vorteil dieser kultivierungsunabhängigen Methode ist die schnelle Auswertung, da die zeitaufwendige Kultivierung entfällt. Allerdings kann nicht zwischen lebenden und abgestorbenen Mikroorganismen unterschieden werden und die Bestimmung von Schimmelpilzgattungen und -arten ist nur sehr eingeschränkt möglich.
Die Luftpartikelsammlung zur Schimmelpilzanalyse mit dieser Methode ist insbesondere für die Überprüfung des Sanierungserfolges wichtig.
Wurden bei der Sanierung Biozide eingesetzt, kann durch die Bestimmung der Gesamtsporenzahl überprüft werden, ob die Schimmelpilze nicht nur abgetötet, sondern nach dem Biozideinsatz auch wirksam entfernt wurden. Dies ist ein entscheidender Schritt zur Überwachung und Verbesserung der Innenraumluftqualität und zur Vermeidung von Gesundheitsrisiken durch Schimmelpilze.
Mikrobiologische Überprüfung von Lüftungs- und Klimaanlagen
Die mikrobiologische Kontrolle von Lüftungs- und Klimaanlagen ist unerlässlich, um Gesundheitsrisiken durch Mikroorganismen wie Bakterien und Pilze in Gebäuden zu minimieren. Beschwerden wie Unwohlsein und Atemwegserkrankungen lassen sich häufig auf die Luftqualität zurückführen, die durch diese Anlagen beeinflusst wird. Insbesondere schlecht gewartete oder unzureichend gereinigte Anlagen können ein Risiko darstellen.





